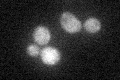
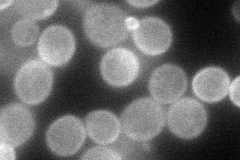
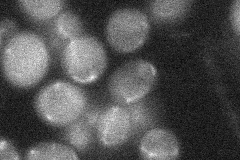
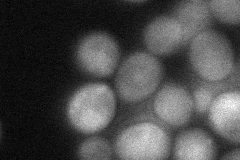
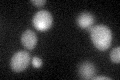

View description
GTPase-activating protein (GAP) for Cin4p; tubulin folding factor C involved in beta-tubulin (Tub2p) folding; mutants display increased chromosome loss and benomyl sensitivity; deletion complemented by human GAP, retinitis pigmentosa 2
Localization:
Intensity:
Fold change:
Significance:
-
C’ GFP library in SD
cytosol27.44 -
N' NOP1pr-GFP in SD
cell periphery81.4407 -
N' TEF2pr-mCherry in SD

cell periphery80.9372 -
N' NATIVEpr-GFP in SD
below threshold20.7733 -
N' TEF2pr-VC and Cyto-VN in SD
cytosol37.9701 -
C’ GFP library in SD+DTT
cytosol24.130.87No -
C’ GFP library in SD+H2O2

cytosol24.730.9No -
C’ GFP library in Starvation Media

cytosol18.40.67No -
C’ GFP library on the background of Pup2-DaMP

cytosol -
C’ GFP library on the background of CCT mutant

cytosol30.94131.12721No
